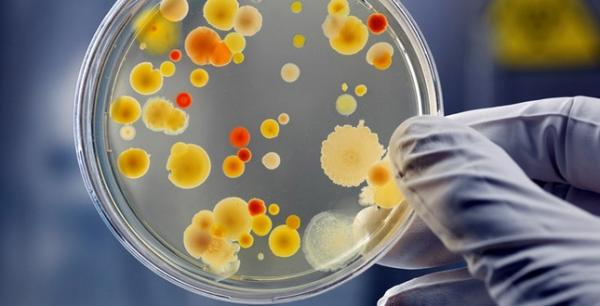

У ще двох прикарпатців медики діагностували ботулізм
13 Травня 2015, 10:23
На Франківщині зареєстровано НС природного характеру, об’єктового рівня, код 20721 «НС, пов’язана з отруєнням людей у результаті споживання неякісних продуктів харчування», ознака 2.36 «Одночасне отруєння людей з одного колективу внаслідок споживання продуктів харчування або води», ботулізм.
Про це повідомляє управління з питань надзвичайних ситуацій ОДА.
За інформацією Івано-Франківського центру екстреної медичної допомоги встановлено, що 12 травня о 15.20 годині до Івано-Франківської обласної інфекційної клінічної лікарні госпіталізовано громадянка, 25.03.1983 р.н. та гргромадянин, 23.03.2006 р.н. жителів с. Сенечів Долинського району. Проведеними лабораторними дослідженнями встановлено остаточний діагноз захворювання – ботулізм. Стан госпіталізованих легкий.
Працівниками Долинського міжрайонного управління держсанепідемслужби України в Івано-Франківській області в осередку захворювання проводиться комплекс санітарно-гігієнічних та протиепідемічних заходів.


